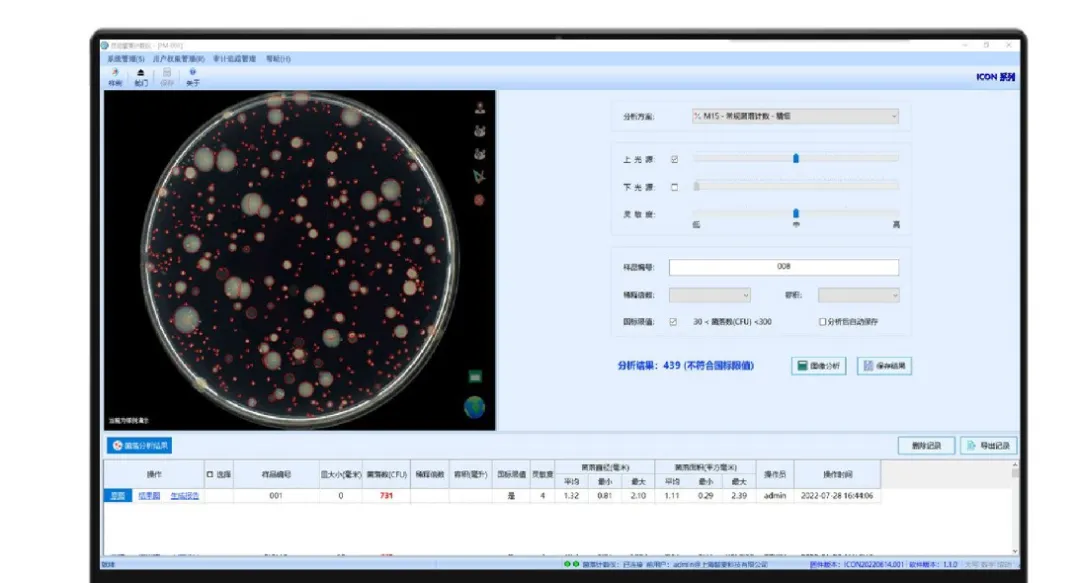
微信圖片_20251219093817_481_102.png

新聞應(yīng)用
更新時間:2025-12-19 瀏覽次數(shù):184
由國家奶業(yè)科技創(chuàng)新聯(lián)盟和國家乳制品質(zhì)量檢驗檢測中心共同指導(dǎo),食品伙伴網(wǎng)主辦,內(nèi)蒙古伊利實業(yè)集團股份有限公司和內(nèi)蒙古蒙牛乳業(yè)(集團)股份有限公司聯(lián)合主辦的“2025(第六屆)乳及乳制品檢測與控制技術(shù)交流會暨第三屆中國乳品創(chuàng)新技術(shù)論壇”于2025年3月20日,在呼和浩特盛大開幕。

此次論壇上,磐麥科技自主研發(fā)的ICON自動菌落計數(shù)儀憑借其AI智能識別與高通量菌落計數(shù)自動化技術(shù),成為大會焦點,為乳制品行業(yè)的高效檢測與質(zhì)量安全升級提供了創(chuàng)新解決方案。

在乳制品生產(chǎn)鏈條中,微生物檢測是保障食品安全的核心環(huán)節(jié)。傳統(tǒng)人工計數(shù)存在效率低、誤差率高、數(shù)據(jù)追溯難等痛點,ICON自動菌落計數(shù)儀通過菌落形態(tài)庫智能匹配與AI自主學(xué)習(xí)的深度融合,實現(xiàn)了4秒/皿的極速計數(shù),菌落識別準(zhǔn)確率高達(dá)98%以上。
乳制品菌落樣品中通常會有很多復(fù)雜樣本,ICON可精準(zhǔn)區(qū)分乳制品常見的氣泡與雜質(zhì),對粘連菌、重疊菌等有精準(zhǔn)的識別,大幅降低誤判和漏數(shù)的風(fēng)險,為嬰幼兒奶粉、液態(tài)奶、奶酪等高附加值品類提供“零漏檢”級質(zhì)量保障。
ICON不僅解決了傳統(tǒng)檢測的效率和精度問題,其數(shù)字化管理功能更推動了實驗室的智能化升級。ICON從圖像采集、數(shù)據(jù)分析到報告生成全程無需人工干預(yù),支持一鍵式操作,符合FDA 21CFR-Part 11、中國GMP等國際數(shù)據(jù)完整性標(biāo)準(zhǔn),通過ICON的數(shù)據(jù)管理系統(tǒng)可以與實驗室信息平臺(LIMS)無縫對接,助力企業(yè)實現(xiàn)“檢測-分析-決策”一體化,極大縮短出廠品控周期。
創(chuàng)新科技/
對于極大通量的菌落計數(shù),ICONSTATION應(yīng)運而生,全面智能計數(shù)的時代來臨,ICON在其軟硬件和性能上得到了大幅的提升,拓展自動化機械手和藍(lán)牙掃碼,用戶無需干預(yù),可實現(xiàn)連無人值守菌落計數(shù),計數(shù)速度達(dá)到13.33秒/皿,單次運行通量可達(dá)160個皿。

近年來,ICON的研發(fā)成果已獲行業(yè)的高度認(rèn)可,未來,ICON將會在‘精準(zhǔn)+速度’雙維突破上持續(xù)發(fā)力,為應(yīng)對全球食品檢測安全提供強有力的工具。
資源
關(guān)于我們
聯(lián)系我們

?2024 上海磐麥科技有限公司 版權(quán)所有 備案號:滬ICP備20012062號-3